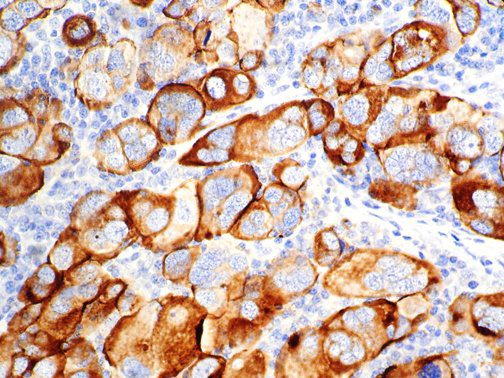
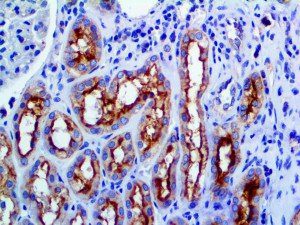
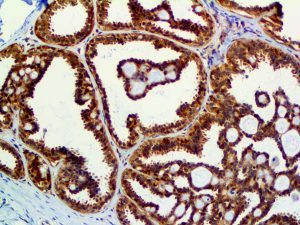
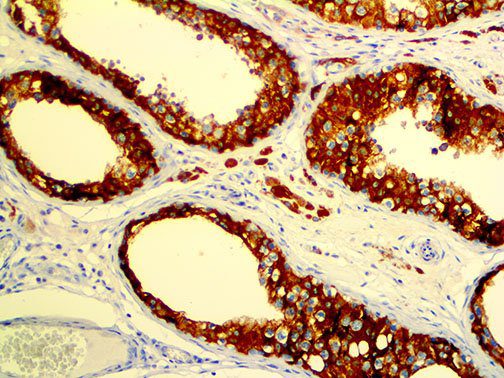
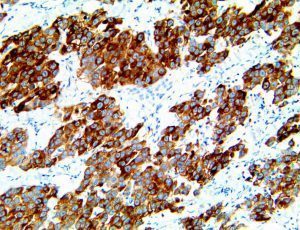
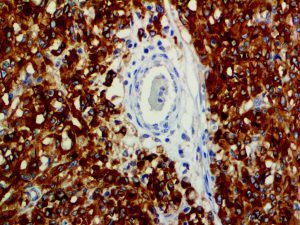
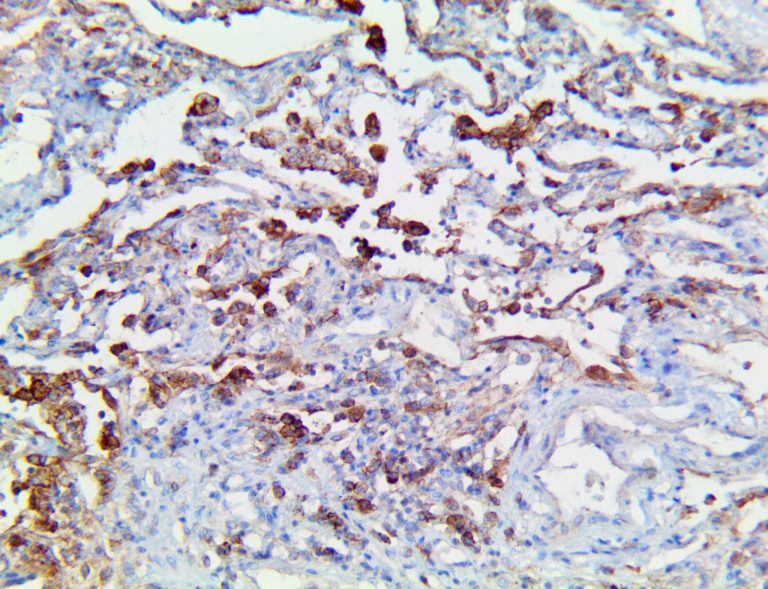
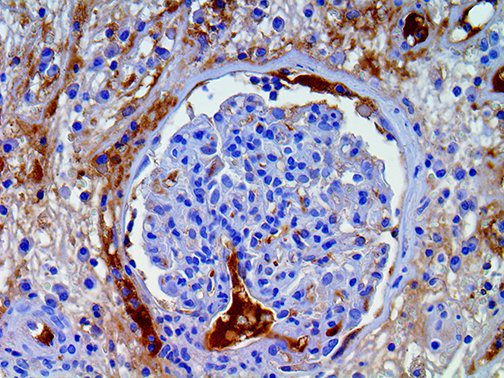
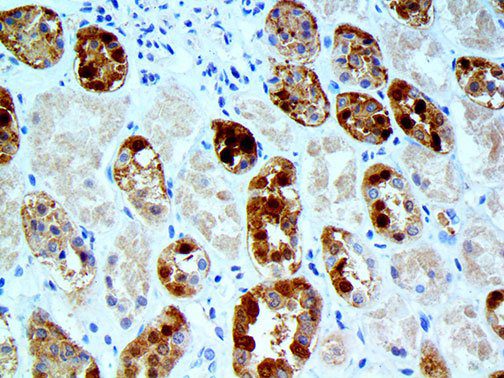
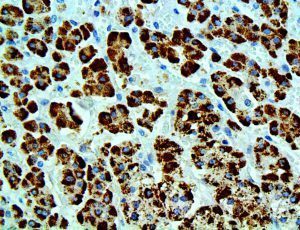
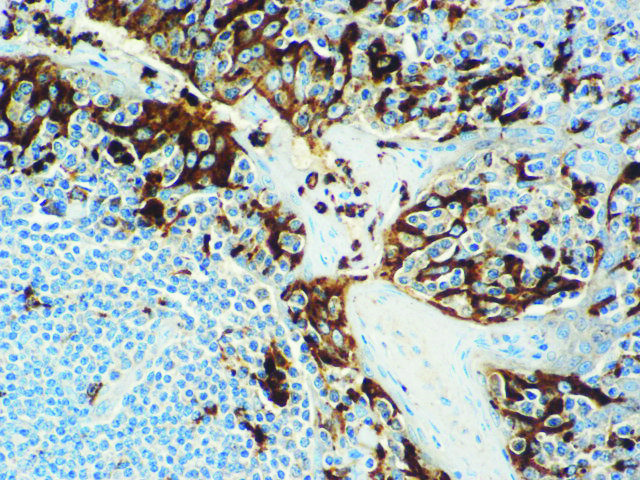
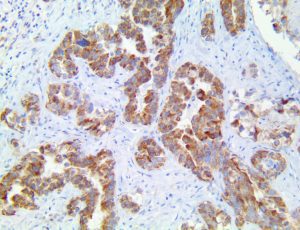
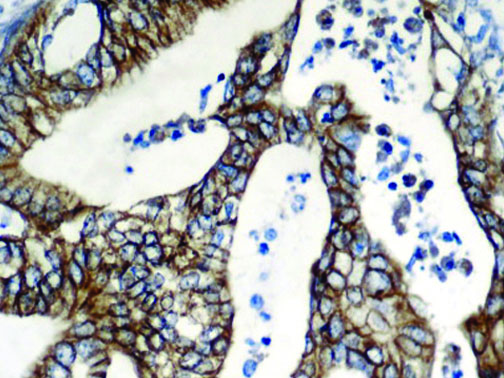
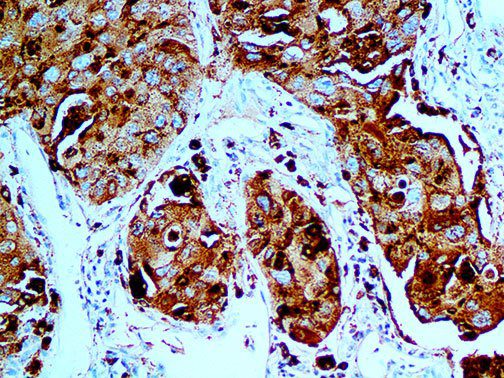
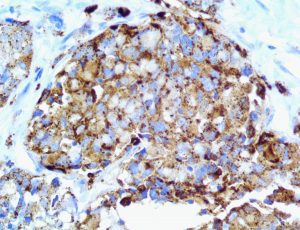
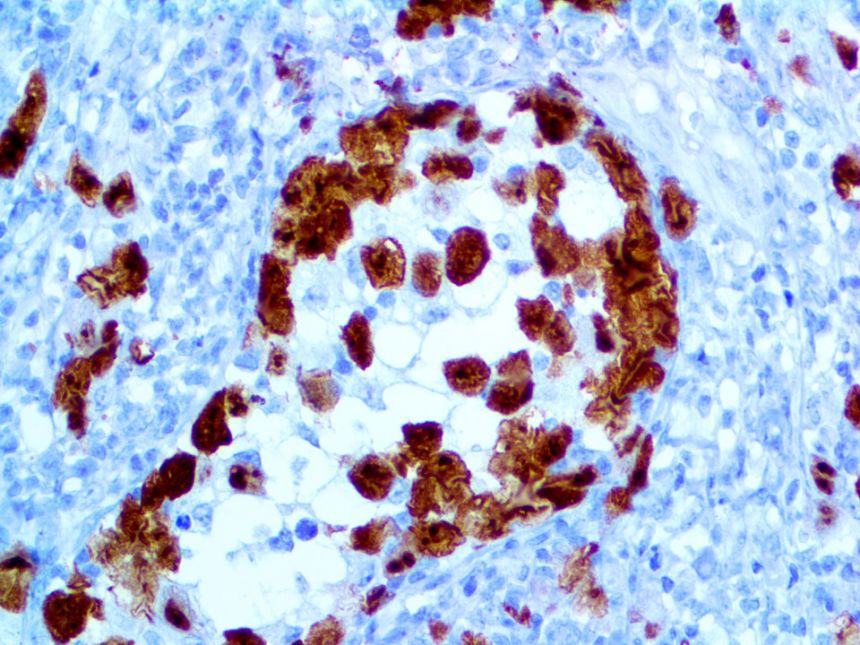
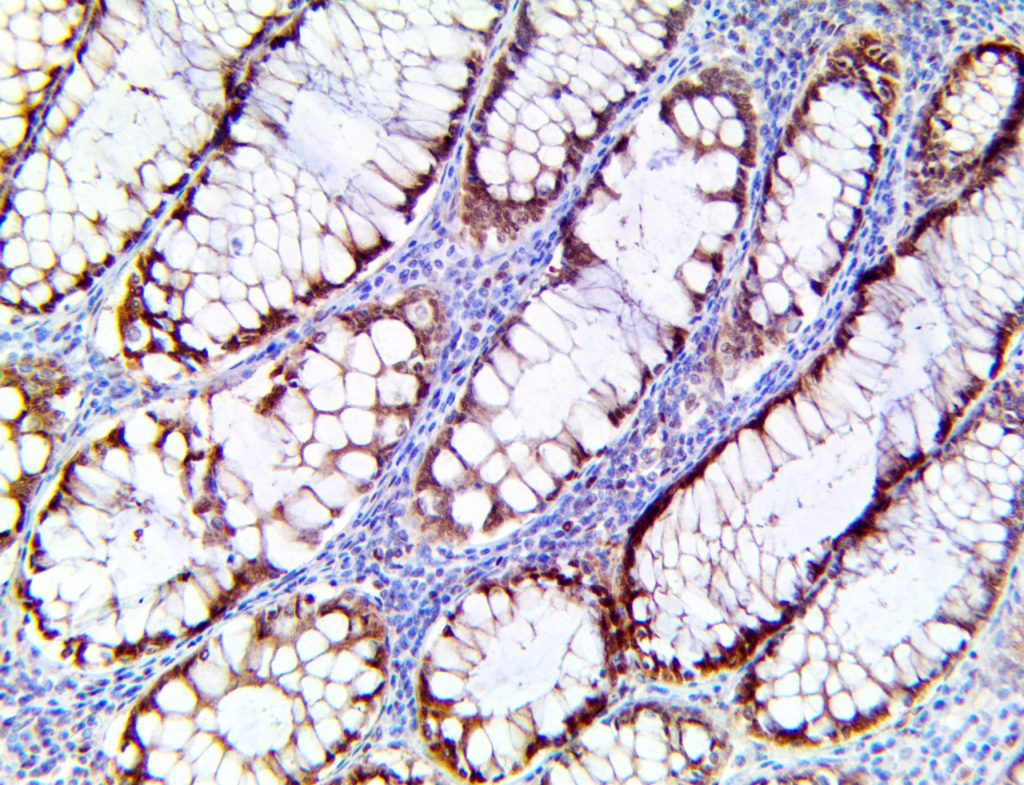
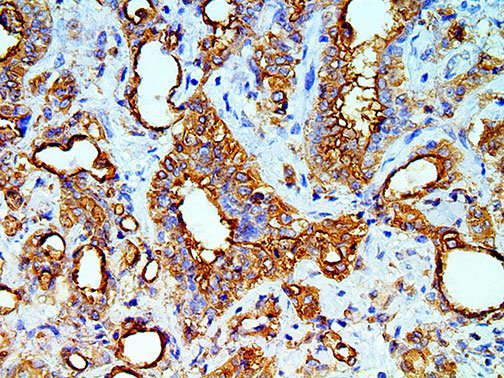
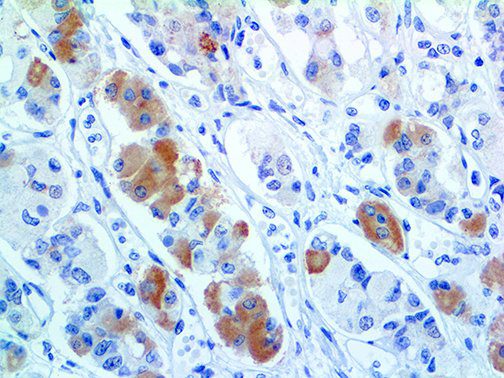
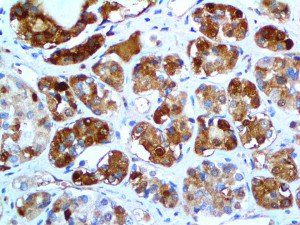
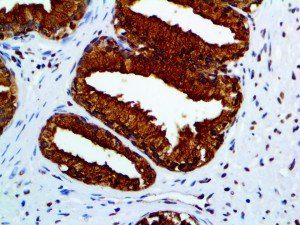
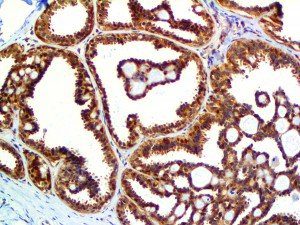

The vast majority of patients with COVID-19 have had a good prognosis, but there are still some critical individuals and even death.10 Most of these critically ill and dead patients do not develop severe clinical manifestations in the early stages of the disease. Some patients only show mild fever, cough, or muscle soreness. These conditions suddenly deteriorate in the later stages of the disease or in the recovery process . Acute respiratory distress syndrome (ARDS) and multiple-organ failure occur rapidly, resulting in death within a short time. Cytokine storm is considered to be one of the major causes of ARDS and multiple organ failure.
Cytokine Storm Syndrome (CSS) is characterized by systemic symptoms and signs derived from a massive and uncontrolled inflammatory response caused by pro- and anti-inflammatory cytokine dysregulation. Viruses, such as Herpes and Epstein-Barr are known to trigger CSS, as is H5N1 influenza. Current literature indicates that SARS-CoV-2 triggers CSS and has been attributed to the severe symptoms’ characteristic of critical patients. CSS in these patients is often fatal, as was the case in the previous SARS and MERS outbreaks.
The first cytokines released are interleukin 1β (IL-1β) and tumor necrosis factor-α (TNF-α), which attract a variety of circulating white blood cells (WBCs) to the infection site, including neutrophils, monocytes, macrophages, and natural killer (NK) cells. This response, along with the antipathogenic chemicals released by these cells (i.e., complement), comprise the innate immune response. These cells directly attack the invading pathogen and also release additional cytokines, chief among them interleukin-1 and 6 (IL-6). IL-6 is essential for invoking the adaptive immune response, which calls T-cells, B-cells, and T helper (Th) cells to the infection site. IL-6 also stimulates further recruitment, proliferation and activation of macrophages.
It is the ICU physician who is most likely to witness one of the deadliest manifestations of the abnormal immunological response, the cytokine storm syndrome (CSS). This response is also referred to by some as the cytokine release syndrome (CRS). CSS is characterized by continuous activation and expansion of macrophage and lymphocyte populations, which secrete large amounts of cytokines, causing the cytokine storm. This massive cytokine release is akin to hemophagocytic lymphohistiocytosis (HLH) disease, a syndrome characterized by initial unchecked and persistent activation of cytotoxic T lymphocytes and NK cells.
Clinical and laboratory manifestations of HLH include fever, enlarged liver and/or spleen, neurologic dysfunction, coagulopathy, liver dysfunction, cytopenias (i.e., low levels of erythrocytes, leukocytes, and/or platelets), hypertriglyceridemia, hyperferritinemia, hemophagocytosis, and eventually diminished NK cell activity as the immune system becomes progressively paralyzed. HLH can be familial (primary HLH) or secondary to another disease process (sHLH), such as rheumatic disease, in which it is referred to as macrophage activation syndrome (MAS, characterized by elevated ferritin).
This activation induces inflammatory monocytes to highly express IL-6, starting a localized and then systemic cascade effect that results in hyperproduction of IL-6, which accelerates the inflammatory process. Because IL-6 also increases vascular permeability, excessive levels cause blood vessels to become very leaky. This, along with clotting factors released from vascular endothelial cells, stimulates the coagulation cascade, resulting in microthrombosis (tiny clots), which leads to ischemia and tissue death of the kidney, intestines, heart, liver, brain and extremities.